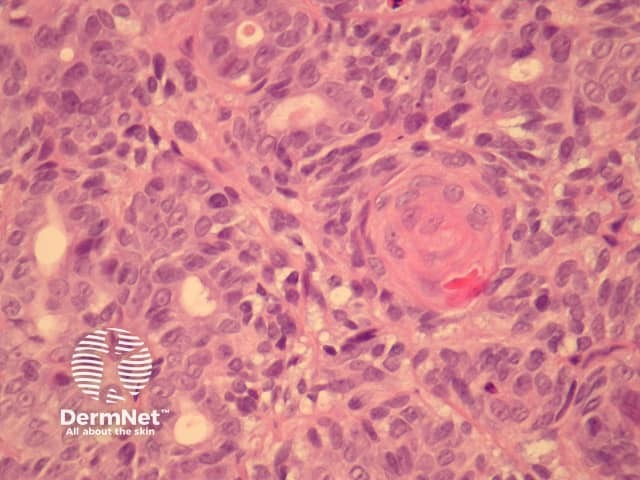
Figure 5
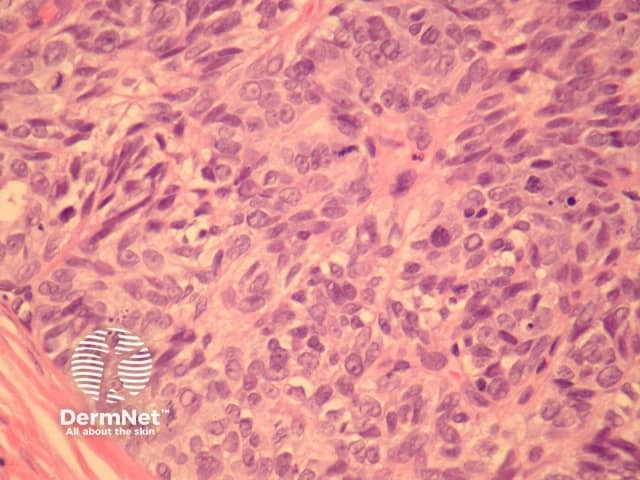
Figure 6

Main menu
Common skin conditions
NEWS
Join DermNet PRO
Read more
Quick links
Author: A/Prof Patrick Emanuel, Dermatopathologist, Auckland, New Zealand, 2014.
Introduction Histology Special studies Differential diagnoses
Aggressive digital papillary adenocarcinoma are acral tumours, which have a broad morphologic spectrum and may cause diagnostic confusion. Previously, tumours would be divided into adenoma and adenocarcinoma based on atypia, but this has been revised: even bland tumours may behave in a malignant fashion.
In aggressive digital papillary adenocarcinoma, sections show a dermally based tumour, which may connect with the overlying epidermis (figure 1). The tumour may be cystic, papillary, ductal or solid. The example illustrated here has a predominantly solid and ductal morphology with only focal areas of papillary formation. The cells are basaloid, show enlarged atypical nuclei, large nucleoli and increased mitoses (figures 1-6). Squamous metaplasia within the tumour may be seen (figure 5).

Figure 1

Figure 2

Figure 3

Figure 4
Figure 5
Figure 6
None are generally needed. In cases which are encountered in lymph nodes immunohistochemical studies to rule out metastasis from breast, thyroid or gastrointestinal sites may be needed.
Metastatic adenocarcinoma – Clinical history and immunohistochemical studies may be needed to rule out a dermal or nodal metastasis from another site.
Benign adnexal tumour – Some of these tumours can be deceptively bland. The acral site, infiltration of deep structures and epidermis and growth pattern helps in arriving at the correct (malignant) diagnosis.